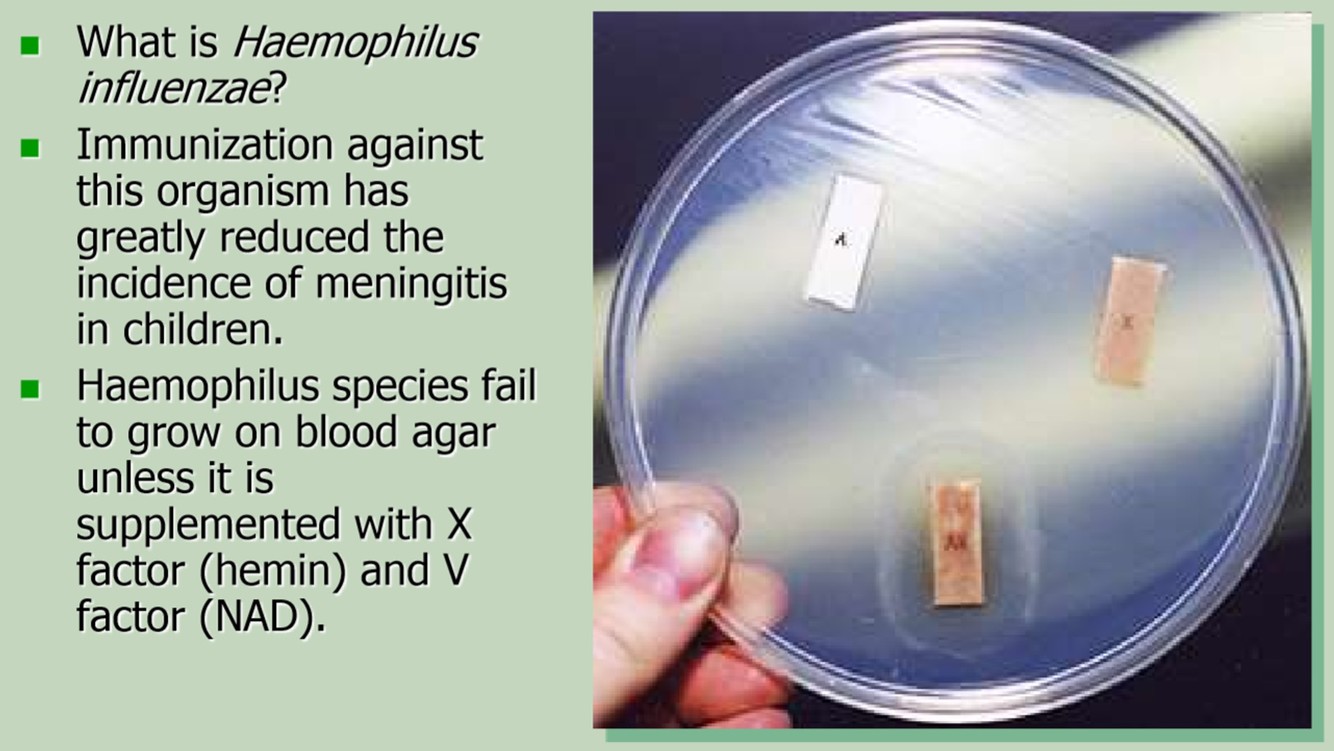

This Gram-negative organism grows well on
McConkey’s agar, is often green in color and
is oxidase positive.
What is Pseudomonas aeruginosa?

This common Gram-negative organism, many cases of which can be prevented by immunization, requires hemin and NAD for growth.
What is Haemophilus influenzae ?
Immunization against this organism has greatly reduced the incidence of meningitis in children.
Haemophilus species fail to grow on blood agar unless it is supplemented with X factor (hemin) and V factor (NAD).
Errors in Gram stain
- Gram-negative called gram-positive
- Gram-positive called gram-negative
- Gram-negative called gram-positive
Acinetobacter
- Gram-positive called gram-negative
Bacillus and Clostridium species typically are – 95% to 100% gram-positive early in their growth phase in broth cultures but become
– 40% to 50% gram-negative in the late growth phase and
– 90% to 95% gram-negative in the stationary phase.
Loss of Gram stain retention associated with aging of the culture most likely accounts for the frequency of misreading for these species.
Culture Media – Selective and Differential
Hectoin Enteric agar
- Selective for enteric bacteria
- Differential for Salmonella & Shigella
16s rRNA Gene Sequencing for Bacteria ID
16s rRNA Gene Sequencing
- highly conserved
- about 1,550 bp long variable and conserved regions.
- conserved regions at the beginning of the gene and at either the 540-bp region or at the end of the whole sequence (about the 1,550-bp region)
- variable region used for comparative taxonomy
MALDI-TOF for Bacteria ID
MALDI-TOF for Bacteria ID
- Matrix-Assisted Laser-Desorption/Ionization Time-of-Flight Mass Spectroscopy.
- Analyzes high-copy proteins in the bacterial cell; mostly ribosomal proteins.
- Sample is spotted onto plate, mixed with matrix, then fed into the instrument.
- Low reagent cost (pennies), extremely fast ID (minutes).
What is Mass Spectrometry and TOF?
Mass Spectrometry
- Charged molecules are accelerated by an electric field in vacuum.
- Requires generating gas-phase ionized material.
- The acceleration is proportional to the mass/charge ratio: m/z
- The charges may be deflected or flung about in various ways in different instruments.
- They’re detected by the charge passing through another electric field.
- Detect 10-15 to 10-18 molar concentrations.
- Time-of-flight (TOF) instrument
- The target is accelerated a defined amount, and flies linearly, without further acceleration, until it is detected.
This Gram-negative organism is best isolated on a selective agar containing cefsoludin, irgasan, and novobiocin?
Yersinia enterocolitica
- CIN agar (Yer-CIN-ia) is used to isolate this organism from the stool
CSF Major pathogens
- How do you detect pathogens?
- Young adults?
- Old adults?
- Babies?
- Fungal?
- Parasite?
CSF Major pathogens:
- Bacteria: cytospin and gram stain
- Young adults:
- N. meningitidis
- Listeria in pregnant women
- Old adults:
- S. pneumoniae
- Antigen in urine
- HSV
- S. pneumoniae
- Babies:
- Listeria
- group B Streptococci
- E. coli
- Fungal:
- Coccidiomycosis
- Cx
- Histoplasma
- Antigen in CSF, BAL, urine
- Cryptococcus (HIV+)
- Antigen in CSF and serum, follow titers
- Candida albicans
- Coccidiomycosis
- Parasite:
- Nagleria
- Look for motility (STAT)
- Nagleria
H. influenzae
in newborns
and newborns
Encephalitis and Brain abscesses
Encephalitis
- Viral usually; rarely rickettsial, syphilis, Lyme.
Brain abscesses
- Contiguous: from sinusitis or otitis media
- Upper respiratory flora
- Often polymicrobial
- Hematogenous, from bacterial endocarditis
- Usually monomicrobial, BE pathogens
Pleural and Peritoneal pathogens
Pleural fluid:
Pneumonia bugs
S. pneumoniae
S. aureus
S. pyogenes
Peritoneal fluid:
GI bugs
E. coli and other gram-negatives
mixed GI flora in surgical patients
GI and skin flora in spontaneous bacterial peritonitis in ascites/liver failure
Joint pathogens
Joints
- Staphylococcus aureus
- Neisseria gonorrhoeae
- Borrelia burgdorferi (Lyme disease)
- Culture / Gram stain for conventional bacteria
- Serology for Lyme
Blood pathogens
Major Blood pathogens:
- S. aureus
- S. coag neg.
- Enterobacteriaciae
- enterococci
- Pseudomonas
- S. pneumoniae
- viridans streptococci
- yeasts
Blood culture
Typical Media:
- blood culture bottles (aerobic ± anaerobic)
- Incubated in automatic reader which detects CO2 production (BactAlert, Bactek) or pressure change (Trek)
- Usually incubate 5 days, occasionally fewer, more for special pathogens ( Brucella , Legionella )
Blood Culture Contamination
Blood Culture Contamination
- Skin flora
- Coagulase-negative staph
- Corynebacterium spp.
- Rarely viridans streps
- A cost issue - Several thousand dollars
- QA guidelines suggest getting rate to 2-3%
- Chlorhexidine or iodine skin preps
- Dedicated IV / blood culture teams
Bloodstream Infections – Bacterial Endocarditis
Bloodstream Infections – Bacterial Endocarditis
Native Valve Endocarditis
- Streptococci, 60-80%
- Viridans streps
- Beta-streps
- Enterococci
- Staphylococci, 20-35%
- S. aureus
- Gram-negatives, 1-5%
- Fungi, others
Prosthetic valve endocarditis
- Coag negative staph
Risk factors – existing valve disease, IVD
Bloodstream Infections – Lines
Bloodstream Infections – Lines
- Coag-negative staph
- Enterococcus
- S. aureus
- Enterobacteriaciae
- Pseudomonas
- Acinetobacter
Maki roll-plate method
- Catheter tip rolled on BAP
- >15 colonies of a single isolate considered significant
- Should be paired with peripheral culture
UTI in Community
- List in order of frequency
- Pathogens and susceptibilities
- Gram + chains?
- Gram + clusters?
UTI in Community
- 95% E.coli
- No resistance
- Klebsiella
- Resistant to ampicillin
- Give ciprofloxacin or nitrofurantoin
- Proteus
- Resistant to nitrofurantoin and tetracyclin
- Give fosfomycin (one dose)
- Group B strep
- Gram + in chains
- Give PCN
- If PCN allery give clyndamycin and erythromycin
- Staph saprophyticus
- Gram + in clusters
- Give cefalosporins
Interpretation of Urine Cultures
- Quantity
- Purity
Interpretation of Urine Cultures
- Quantity important;
- >10^5 significant, >10^4 possibly significant
- 10^2/ml in sterile collection technique
- 10^2/ml in pregnancy
- Purity is important:
- 1 isolate, likely
- 2 isolates, perhaps
- ≥3 isolates, contaminated
- Special populations: spinal cord injury, neurogenic bladder
Pneumonia in Community
- Ambulatory
- Older patients
Pneumonia in Community
Ambulatory
- Mycoplasma
- Dx serologically (IgM) or by molecular
- Give erythromycin or tetracyclin
- Legionella
- Urine antigen only detects legionella pneumophila type 1
- If negative Cx or DFA bronchoscopy specimen
- Haemophilus influenzae
- Give rocephin or ceftriaxone
Older patients
- Strep pneumoniae
- Urine antigen
- Cx resp specimen
- MRSA
Pneumonia in Hospital
Pneumonia in Hospital
- Moraxella
- aspiration
- pure Cx
- Give non-Betalactams
- Klebsiella and Pseudomonas
- Gram -
- Water
Bronchitis
Bronchitis
- Culture results don’t correlate with symptoms
- H. influenzae
- S. pneumoniae
- Moraxella catarrhalis
- Viruses may be important in exacerbations
- influenza
- parainfluenza
- RSV
- human metapneumovirus
Lung abscess
Lung abscess
- Destruction of lung parenchyma to produce cavities with air-fluid levels
- Usually polymicrobic with anaerobes and upper respiratory tract flora:
- Peptostreptococcus
- Prevotella
- Bacteroides (nonfragilis )
- Fusobacterium
- occasionally
- Clostridium, Actinomyces, alpha-hemolytic Streptococcus, Enterobacteriaceae.
Grading Sputum
Grading Sputum
- Squamous Screen
- Acceptable: <10 SEC / 10x field
- Unacceptable: >10 SEC / 10x field
- Murray and Washington
- Culture only group 5 ( >25 WBC and <10 SEC)
- And culture if >10 WBC and <10 SEC
























































